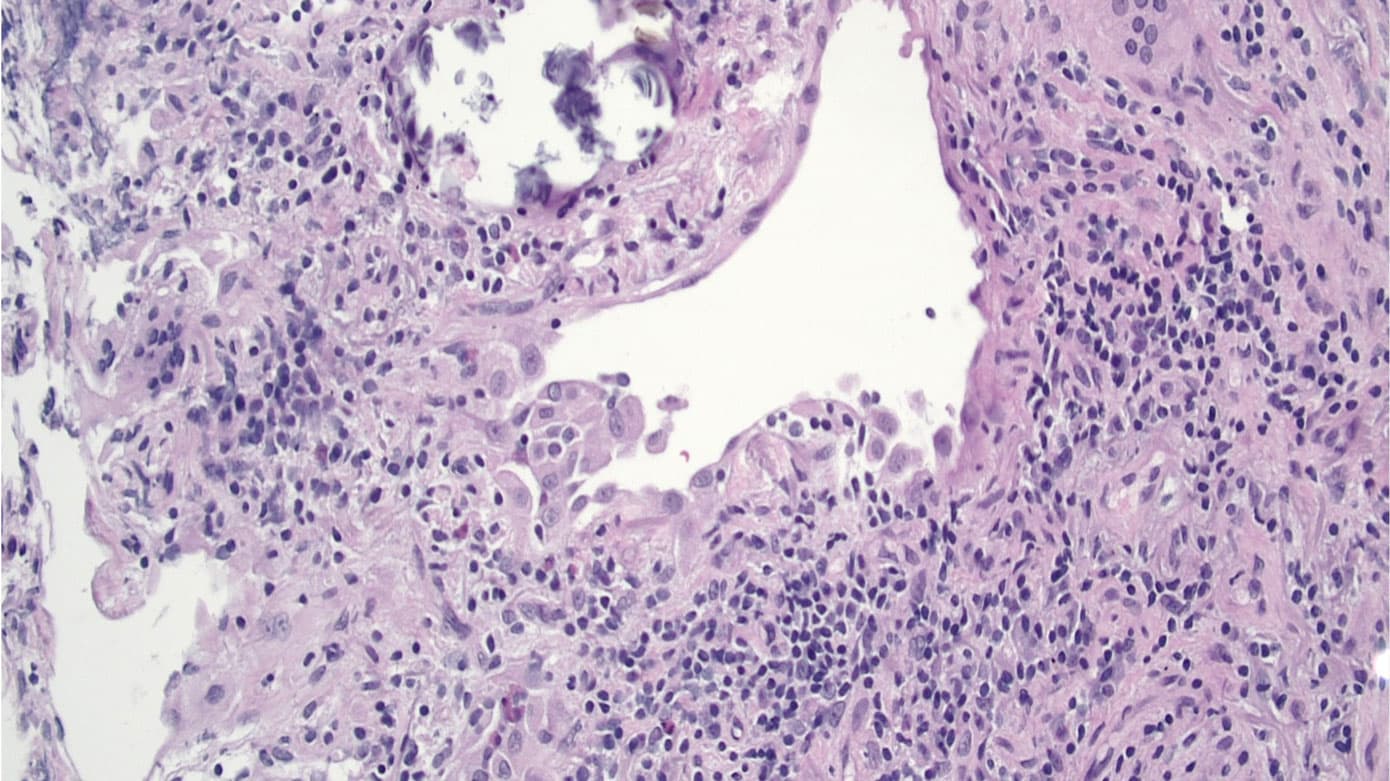
cover

Ny definition og behandlingsmuligheder for allergisk alveolitis

Nanna Makholm Østergård1, 2, Janne Møller3, Sissel Kronborg-White3, Thomas Skovhus Prior3, Line Kølner-Augustson4, Inge Brosbøl Iversen5, Henrik Kolstad5, 6 & Elisabeth Bendstrup3, 6
Hovedbudskaber
Allergisk alveolitis (AA) er en nonfibrotisk (inflammatorisk) og/eller fibrotisk lungesygdom forårsaget af en immunmedieret reaktion på et kendt eller uerkendt antigen.
Eliminering af det udløsende antigen er den vigtigste behandling.
AA behandles med prednisolon og ved progressiv fibrose med antifibrotika.
Allergisk alveolitis (AA) er en interstitiel lungesygdom (ILS) forårsaget af immunologisk reaktion på et inhaleret antigen. AA er en sygdom med mange fænotypiske præsentationer fra inflammatorisk sygdom med mulighed for komplet remission til svær, progredierende, fibrotisk lungesygdom. Fænotypen har betydning for prognose og behandling. I denne statusartikel gives et overblik over udredning og behandling af patienter med AA.
AA blev tidligere defineret på baggrund af kliniske og parakliniske karakteristika samt en erkendt eksponering. Mange studier har vist, at man hos op mod 60% af patienterne ikke kan påvise et specifikt udløsende antigen [1]. Ligeledes har AA tidligere arbitrært været inddelt i en akut, subakut og kronisk form, men i nogle studier var tilstedeværelse af fibrose, enten radiologisk eller patologisk, bestemmende for behandlingsrespons og prognose [2, 3]. Derfor er AA nu i den første, internationale, diagnostiske guideline defineret som en »nonfibrotisk (inflammatorisk) og/eller fibrotisk sygdom, der påvirker lungeparenkymet og de små luftveje. AA er forårsaget af en immunmedieret reaktion på et inhaleret antigen, men påvisning af en specifik udløsende årsag er ikke længere påkrævet« [4].
Udløsende antigen
Over 300 forskellige antigener kan give AA og heraf de fleste i kasuistikker og i forbindelse med enkeltudbrud. Relevante allergener varierer afhængigt af geografisk region, men er som regel proteiner fra dyr, svampe eller mikroorganismer [5]. Flere antigener er allestedsnærværende, og deres tilstedeværelse udgør ikke i sig selv en risikofaktor [6]. Der er evidens for årsagssammenhæng ved høje eksponeringsniveauer for mikroorganismer og andre antigener [7]. Fuglefjer og -fæces er blandt de hyppigere årsager til AA i Danmark.
Immunologisk reaktion
Inhalation af allergen udløser hos modtagelige patienter en inflammatorisk reaktion i lungerne med humorale (antigenspecifikke immunglobulin (Ig) G-antistof-medierede) og cellulære (T-hjælper-celle-medierede) immunkaskader, som medvirker til AA [8]. Rekruttering af makrofager og dannelse af multinukleære kæmpeceller og granulomdannelse samt rekruttering af lymfocytter resulterer i lymfocytinfiltration. Denne infiltration foregår fortrinsvis i bronkiolevæggene, breder sig ud i det peribronkiolære interstitium og medfører obstruktion af bronkiolerne og dermed den karakteristiske air trapping, der ses på højopløseligheds-CT (HRCT) [8].
Den inflammatoriske proces kan ændre karakter med apoptose af epitelet og patologisk fibroblastaktivitet i lungeparenkymet medførende fibrosedannelse [4]. Fibrosen er ofte peribronkiolær, men breder sig ud i det øvrige lungeparenkym, hvorved sygdommen bliver svær at skelne fra andre fibrotiske ILS.
Den genetiske baggrund for AA er dårligt belyst. Hyppigheden af flere gener er øget hos individer med AA, men intet gen er entydigt sammenkædet med sygdomsudvikling [4, 8]. Rygning har en dobbeltrettet effekt, hvor kortvarig rygning hæmmer den inflammatoriske proces, mens langvarig rygning øger inflammation og risiko for at udvikle fibrotisk AA [9].
Forekomst af AA afhænger af klima, kultur og arbejdsforhold m.m. Tærskerlunger er hyppigere i våde, kolde regioner, mens dueholderlunger er hyppige i f.eks. Mexico og Indien. I et dansk studie fandt man en AA-incidens på 1,16/100.000 personer i 1998-2009 [10]. Hyppigheden af AA er stigende, og et studie rapporterede estimerede etårsprævalenser i 2004 og 2015 på hhv. 1,67 og 2,71 pr. 100.000 indbyggere. Prævalensen steg med alderen og var i 2015 11,2/100.000 indbyggere hos personer over 65 år [11].
Diagnose af AA er baseret på en multidisciplinær tilgang med inddragelse af kliniske (herunder relevante eksponeringer), radiologiske og nogle gange histopatologiske undersøgelser med bronkoalveolær lavage (BAL) og lungebiopsi. Alle under udredning for ILS bør have udført udvidet lungefunktionsundersøgelse og biokemisk undersøgelse for anden underliggende sygdom. Grundig anamnese med fokus på mulig eksponering for antigener både i hjemmet, ved tidligere eller aktuelle arbejdsforhold og fritidsbeskæftigelser er væsentlig.
Internationale guidelines inddeler de radiologiske og histologiske forandringer ved både nonfibrotisk og fibrotisk AA i tre grupper vedr. deres betydning for diagnosen: lav, moderat eller høj konfidens. Ved multidisciplinært team (MDT)-konference vurderes HRCT, histopatologi, BAL og eksponering, og AA diagnosticeres efter de tre konfidensniveauer (Figur 1).
Ifølge de internationale guidelines er der ikke behov for en lungebiopsi ved identificeret allergen, BAL med lymfocytose og typisk AA-mønster på HRCT, mens biopsi overvejes, hvis disse kriterier ikke er opfyldt [4] (Figur 1 og Figur 2). På centre, hvor kryobiopsier er implementeret, udføres der ikke transbronkiale tangbiopsier længere. Ved tegn til fibrose anbefales kryobiopsi som første valg. Kirurgisk biopsi bør kun overvejes, hvis anden udredning ikke har givet en sikker diagnose.
Diagnosen kan være udfordrende, da samme fund kan ses ved andre typer ILS. Differentialdiagnostisk kan blandt andet infektioner og rygerelateret ILS overvejes ved nonfibrotisk AA, mens andre typer fibrotisk ILS, specielt idiopatisk pulmonal fibrose, kan ligne fibrotisk AA. Påvist eksponering, BAL med lymfocytose og inflammation i lungebiopsier tyder på AA.
Kliniske manifestationer
AA præsenterer sig typisk ved åndenød og hoste og kan derfor ligne mere almindelige lungesygdomme som astma eller KOL [12]. Der kan være almensymptomer som vægttab, ledsmerter, feber og kvalme. Symptomerne på både fibrotisk og nonfibrotisk AA kan opstå over dage til uger eller mere snigende over måneder til år [13]. Nogle patienter oplever tilbagevendende episoder med symptomer eventuelt i relation til eksponering.
Objektivt kan ses fin krepitation og »knirkelyde« (squeaks) ved lungestetoskopi og i mere avancerede tilfælde trommestikfingre, urglasnegle og perifer cyanose. Flertallet af patienter har en restriktivt nedsat lungefunktion og diffusion. Obstruktivt mønster er beskrevet.
Patienter med fibrotisk AA er ofte ældre, det udløsende antigen er ukendt, og patienternes lungefunktion er typisk mere nedsat end hos patienter med nonfibrotisk AA.
Eksponering
Spørgeskemaer til gennemgang af mulige eksponering bruges tit, men der eksisterer ikke validerede spørgeskemaer [14].
Præcipiterende IgG-antistoffer kan understøtte diagnosen AA ved specifik mistanke om et muligt antigen, men kan i sig selv ikke be- eller afkræfte AA og er alene udtryk for en forudgående eksponering for et potentielt AA-fremkaldende antigen. Der er dog påvist stigende risiko for AA ved stigende IgG-niveauer for kendt antigen [15]. Det diagnostiske bidrag begrænses af, at der ikke findes standardiserede test, og at der mangler test for flere antigener.
Ved mistanke om eksponering for mikroorganismer bør luftbåren eksponering både indendørs og udendørs kvantificeres med standardiseret målemetode (f.eks. som colony-forming units/m3 luft), hvilket gør det muligt at sammenligne med kendte eksponeringsniveauer [6].
Radiologi
Billeddiagnostikken ved AA baseres på HRCT uden kontrast i to faser: den første under dyb inspiration, som viser infiltration af lungevævet, og den anden efter fuld eksspiration, hvor man vurderer lobulær air trapping.
Ved nonfibrotisk AA ses overvejende inflammatoriske og potentielt reversible forandringer, typisk som matglastegning og mosaikattenuering. Forandringerne er oftest symmetriske med diffus fordeling.
Ved fibrotisk AA ses fibrose med irregulær eller grov retikulering, varierende grader af inflammation og traktionsbronkiektasier i områder med matglastegning. Bikagetegning kan ses, men er ikke dominerende [16]. Fibroseforandringerne er oftest dominerende i midt- eller midt-/nedre lungezoner eller ligeligt distribueret i de tre lungezoner med relativt basal sparring. Hos begge typer AA ses forandringer, der indikerer small airways disease: vagt tegnede centrilobulære noduli og lobulær air trapping [17]. Ved fibrotisk HP ses three-density pattern med tydeligt afgrænsede hypo- og hyperattenuerede områder i kombination med normalt lungevæv (Figur 3).
Patologiske fund
BAL med differentialtælling af leukocytter anbefales ved mistanke om både nonfibrotisk og fibrotisk AA. BAL viser typisk lymfocytær inflammation (20-70%) med tendens til lavere lymfocyttal, jo mere fibrotisk tilstanden er.
Histologisk ses interstitiel, lymfocytær infiltration især omkring bronkiolerne, cellulær kronisk bronkiolitis og svagt definerede nonnekrotiserende granulomer. Ved fibrotisk AA er disse træk kombineret med interstitiel og luftvejscentreret fibrose [18].
Tidlig diagnose er vigtig, idet sygdommen ved debut er potentielt reversibel, og eliminering af det udløsende antigen er den mest afgørende faktor for behandlingen [1, 19]. I praksis er det ikke altid muligt at identificere det udløsende antigen, og i nogle tilfælde er eliminering af ekspositionen umulig at gennemføre. Samarbejde med arbejdsmedicinere med rådgivning om, hvordan eksponeringskilder identificeres og undgås, anbefales [20].
Medikamentel behandling
Den medikamentelle behandling af AA er antiinflammatorisk og består hovedsageligt af kortikosteroid, der kan bedre lungefunktionen på kort sigt. Der er dog ingen evidens for, at steroid ændrer langtidsprognosen eller bremser udviklingen af fibrotisk AA [21, 22]. Enkelte retrospektive studier har vist, at brug af steroid til fibrotisk AA er relateret til en dårligere prognose [23]. Ved AA, intolerable bivirkninger eller recidiv under nedtrapning tillægges typisk steroidbesparende immunosuppresiva som azathioprin eller mycophenolatmofetil [24]. Prednisolon startes typisk i dosis på 0,5-1 mg/kg/dag og nedtrappes langsomt efter klinisk respons og lungefunktion. Den samlede behandlingsvarighed for nonfibrotisk AA er normalt 4-6 mdr., mens fibrotisk AA oftest kræver længere behandling.
Progressiv pulmonal fibrose
Patienter med fibrotisk AA kan udvikle progredierende sygdom med forværring af fibrose på HRCT, faldende lungefunktion og stor symptombyrde med høj mortalitet (progressiv pulmonal fibrose) [11, 25]. Studier har vist, at faldet i forceret vital kapacitet (FVC) og overlevelse er sammenlignelige hos patienter med hhv. progressiv fibrotisk AA og idiopatisk pulmonal fibrose [26].
I nogle studier reducerede behandling med tyrosinkinasehæmmeren nintedanib faldet i FVC hos patienter med progressiv fibrotisk AA [27]. I andre studier sås en lignende effekt med pirfenidon, men disse studier havde for lav styrke til med sikkerhed at kunne påvise effekten [28, 29].
Lungetransplantation
En mindre gruppe patienter med svær sygdom kan vurderes mhp. lungetransplantation. Et studie har vist, at etårs-, treårs- og femårsoverlevelsen for 31 lungetransplanterede patienter med AA var hhv. 96%, 89% og 89% [30].
AA har en meget varierende prognose, afhængig af graden af fibrose. Forløbet varierer fra hurtig regression og eventuelt komplet remission efter eliminering af udløsende antigen hos patienter med nonfibrotisk AA til progressiv pulmonal fibrose uden mulighed for helbredelse [13].
AA er en kompleks og heterogen sygdom, og diagnosen kan være udfordrende på grund af overlap med andre ILS. Ved mistanke om ILS på HRCT er en grundig anamnese i forhold til potentielt udløsende agens afgørende. Diagnosen stilles på baggrund af erkendt eksponering og HRCT, men BAL og lungebiopsi kan være nødvendige for at opnå konfident diagnose. Prognosen for AA er afhængig af graden af fibrose på HRCT og eventuelt histologi, og den varierer fra nonfibrotisk sygdom med mulighed for komplet remission til svært fibrotisk sygdom med dårlig prognose. Grundstenen i behandlingen af AA er eliminering af det udløsende antigen. Patienter med AA og påvirket lungefunktion behandles med prednisolon og eventuelt steroidbesparende antiinflammatoriske lægemidler. Patienter med progressiv fibrotisk AA kan tilbydes antifibrotisk behandling.
Korrespondance Nanna Makholm Østergård. E-mail: nanmak@rm.dk
Antaget 20. februar 2024
Publiceret på ugeskriftet.dk 1. april 2024
Interessekonflikter Der er anført potentielle interessekonflikter. Forfatternes ICMJE-formularer er tilgængelige sammen med artiklen på ugeskriftet.dk
Referencer findes i artiklen publiceret på ugeskriftet.dk
Artikelreference Ugeskr Læger 2024;186:V11230705
doi 10.61409/V11230705
Open Access under Creative Commons License CC BY-NC-ND 4.0
In this review, we discuss a new definition and treatment options of allergic alveolitis (AA). AA is an immune-mediated interstitial lung disease triggered by inhaled antigens, it is defined as non-fibrotic (inflammatory) and/or fibrotic, and diagnosis relies on a multidisciplinary approach using clinical, radiological and sometimes histological assessments. Treatment involves early antigen elimination and may include corticosteroids or other immunosuppressants. Prognosis varies from reversible inflammation to irreversible fibrosis. Early detection is crucial for better outcomes.